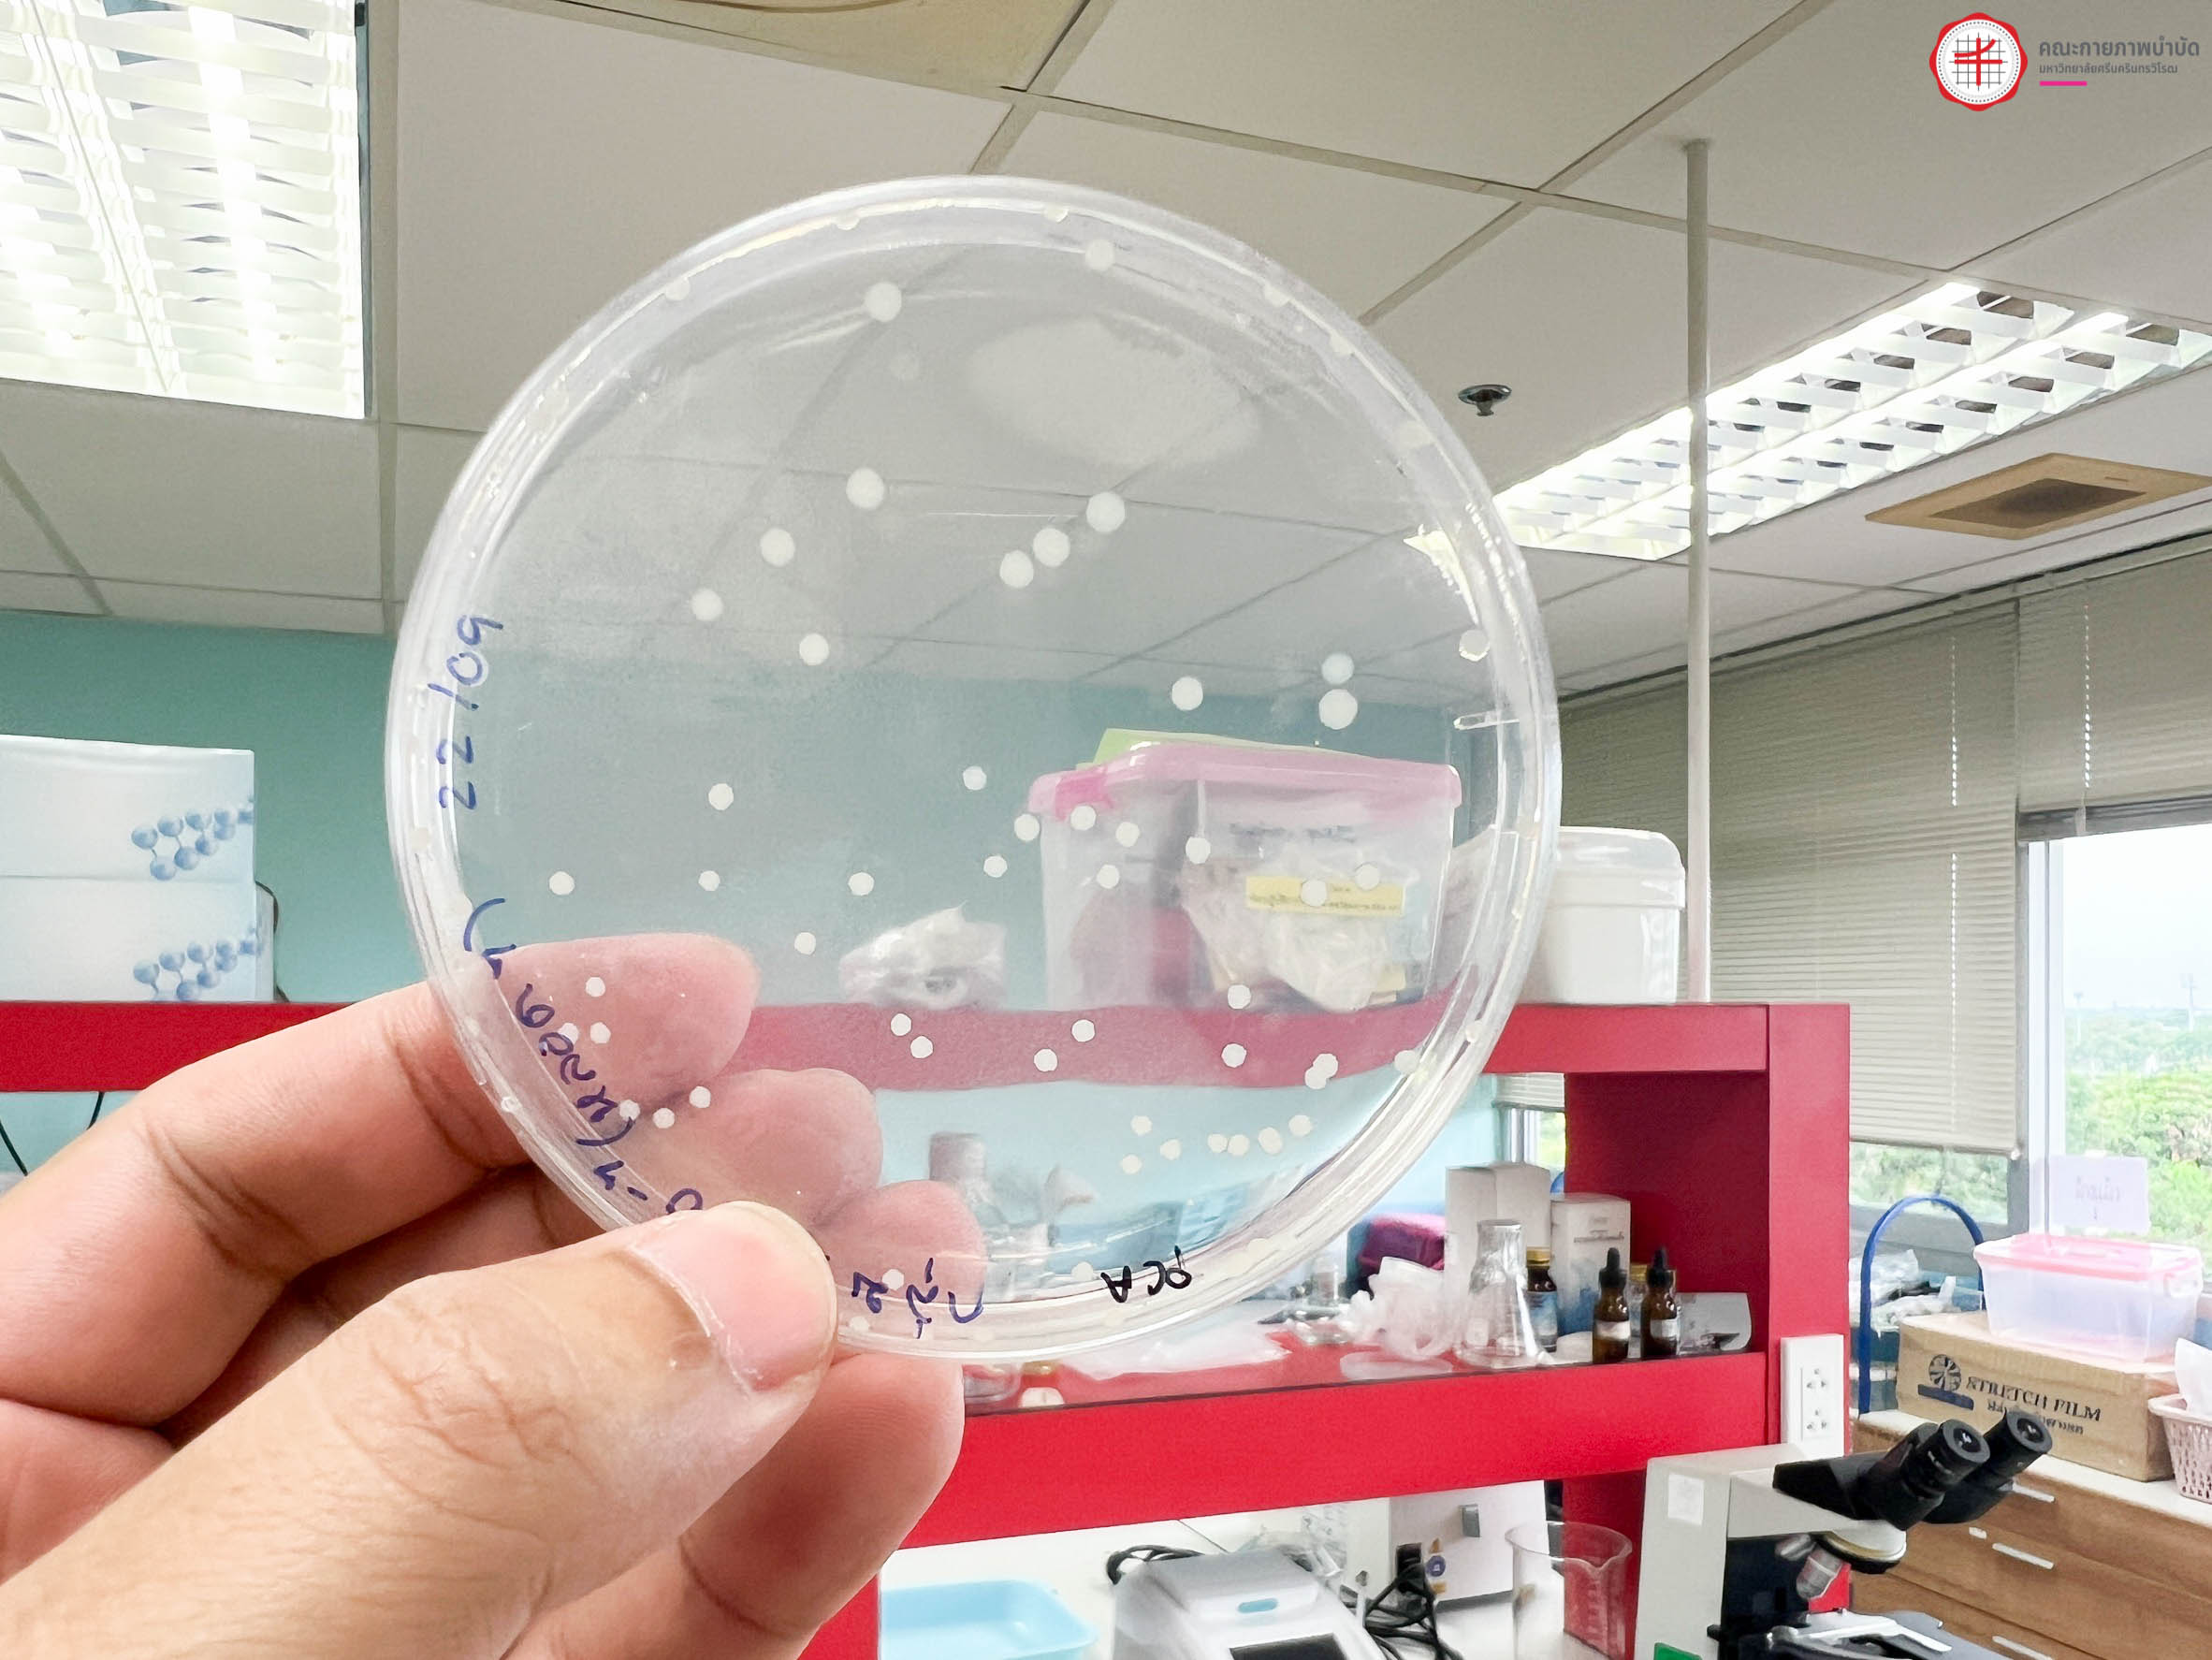
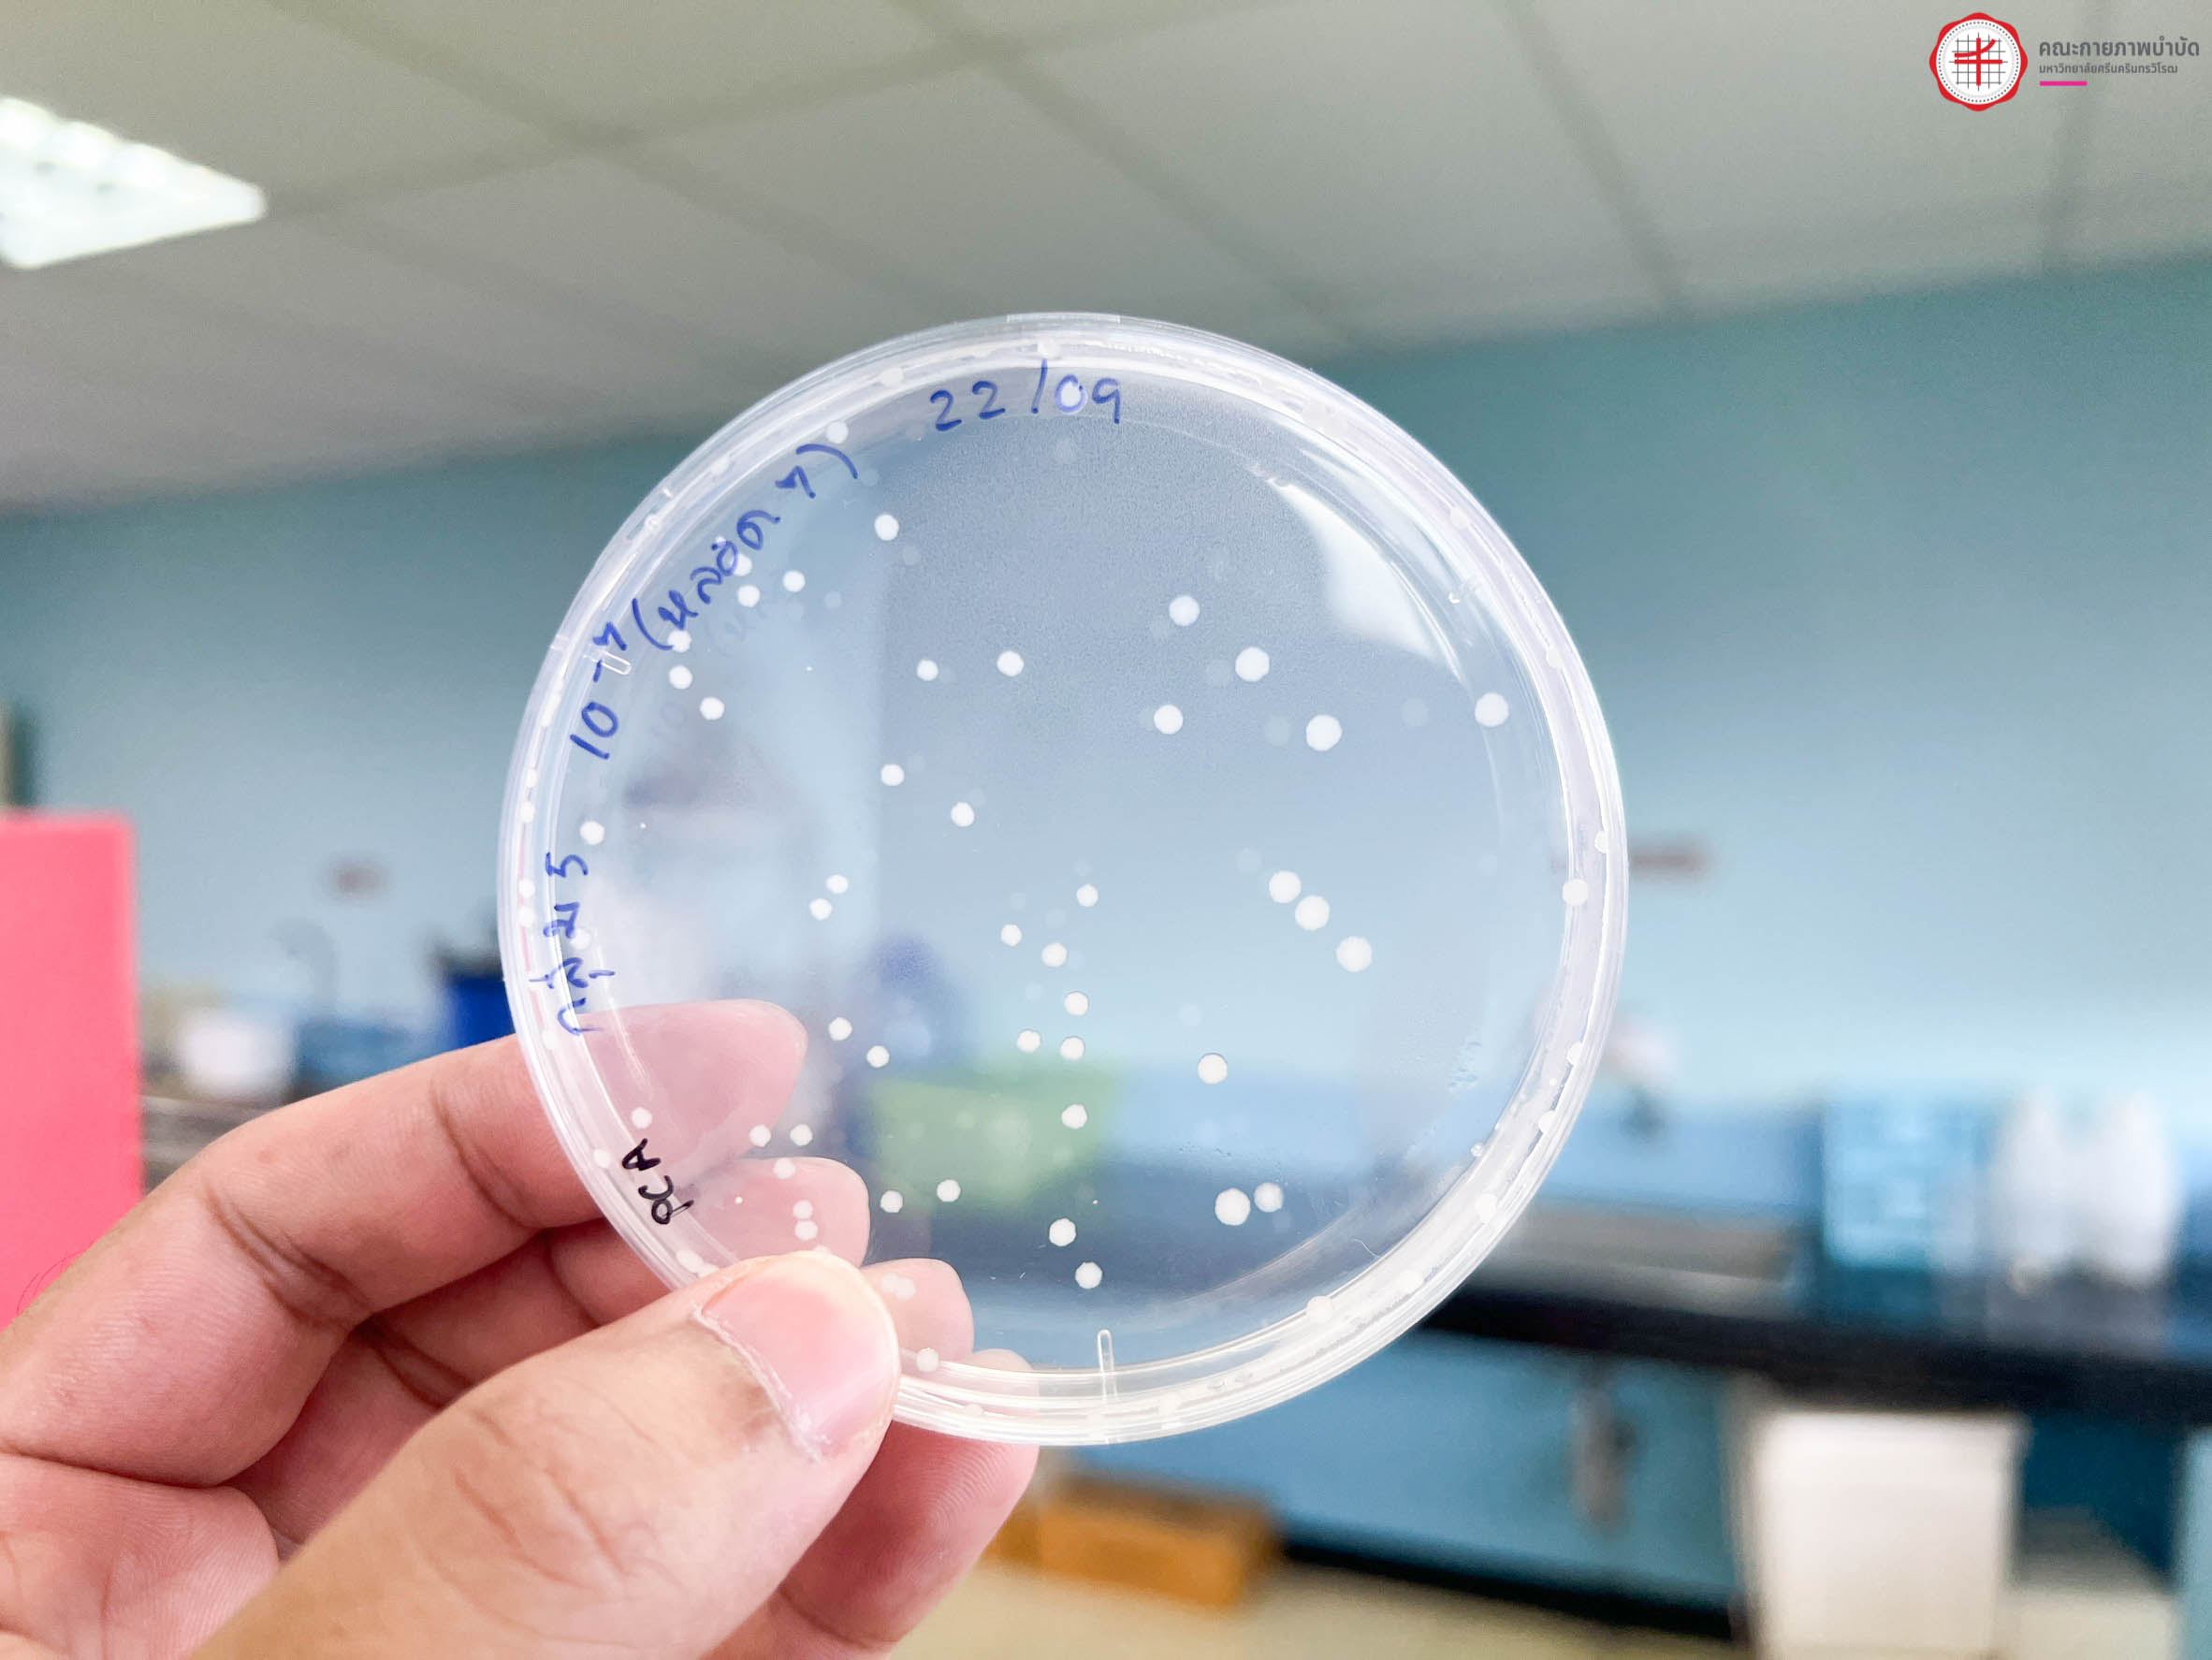

ข่าวประชาสัมพันธ์
[ สาขาการส่งเสริมสุขภาพ ]  เรียนรู้แบบลงมือจริง สนุก เข้มข้น ได้ทักษะจริง!
เรียนรู้แบบลงมือจริง สนุก เข้มข้น ได้ทักษะจริง!
รายวิชา HPX111 จุลชีววิทยาและปรสิตวิทยาสำหรับสาธารณสุข
พานิสิตเข้าสู่ห้องปฏิบัติการทางสุขภาพ เพื่อฝึกตรวจหาเชื้อแบคทีเรียก่อโรคในอาหาร ตั้งแต่ขั้นตอนการเตรียมตัวอย่าง การเพาะเลี้ยงเชื้อ ไปจนถึงการส่องกล้องจุลทรรศน์อย่างมืออาชีพ
คือจุดเริ่มต้นของเส้นทางที่ใช่สำหรับคุณ 
วันเริ่ม